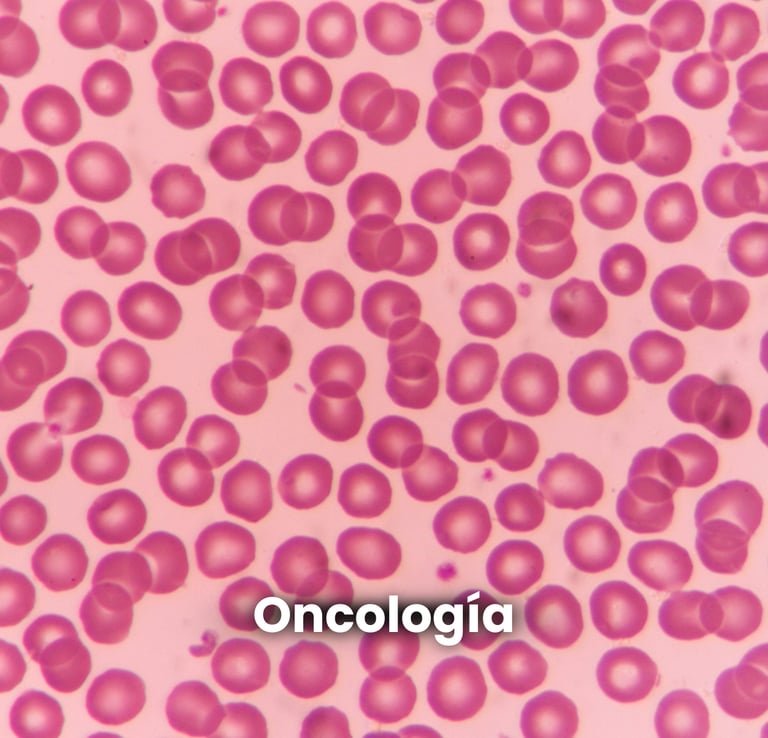
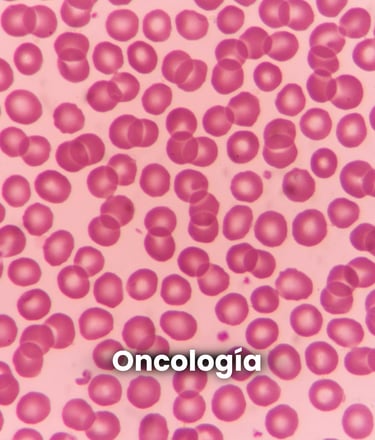

Avenida Flota de Indias 2, local B (41011) 955 11 78 33 | Urgencias: 609 201 081
Servicios veterinarios

Servicio veterinario de urgencias 24h en Sevilla
Ponemos a su disposición un teléfono de urgencias veterinarias que permanece activo los 365 días del año, 24 horas al día, para solucionar cualquier problema que te pueda surgir fuera de horario.
Las urgencias se atienden en nuestra clínica veterinaria en Los Remedios, ya que se encuentra perfectamente equipada para resolver cualquier situación de urgencia.